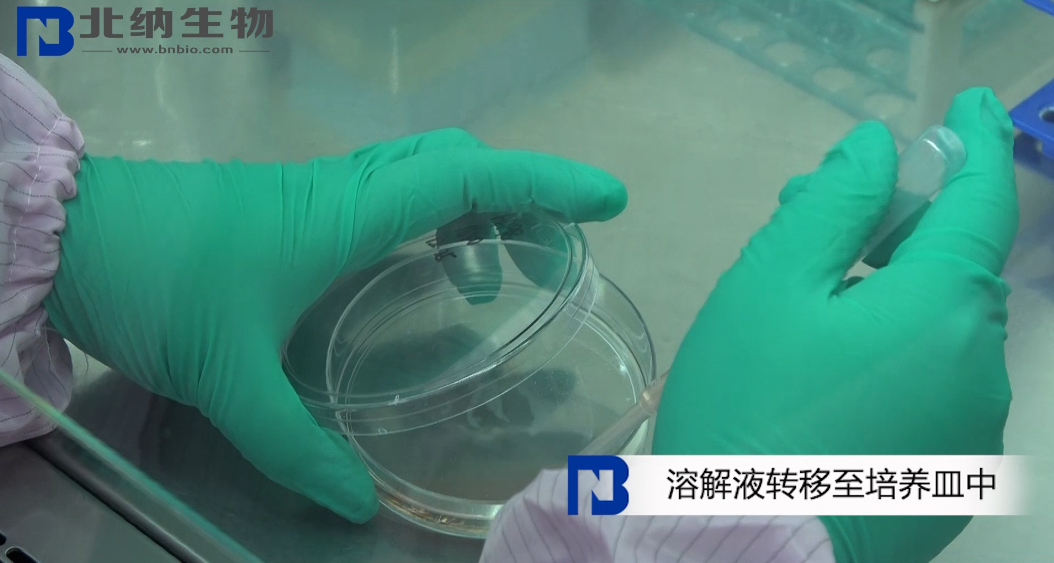
新闻图片12

北京北纳创联生物技术研究院
14 年
手机商铺
商家活跃:
产品热度:
- NaN
- 0.20000000000000018
- 0.20000000000000018
- 2.2
- 2.2
北纳创联地中海诺卡氏菌
询价
推荐产品
公司新闻/正文
冻存细胞到货后如何处理及复苏?
1871 人阅读发布时间:2020-05-08 17:16
本期主要内容是:客户在北纳生物购买冻存细胞,到货后如何处理及复苏?以下是研发中心老师的几点方法,供大家参考。
一、收到冻存细胞怎么处理
1. 收到冻存细胞后,请打开包装箱
2. 检查箱内干冰是否充足,冻存管是否融化
3. 若已经融化,请拍照留存,并于 24h 内联系客服
4. 若无异常,请及时将冻存管置于超低温冰箱内保存
5. 若长时间不使用,必须在超低温冰箱内过夜后转移至液氮中保存
二、冻存细胞复苏

1. 100mm 培养皿做好标记
2. 加入预热好的 12ml 完全培养基

3. 将冻存管放入 37℃ 水浴锅中,轻轻摇晃冻存管,待细胞悬液完全溶解后,转移至安全柜中操作
4. 用无菌吸管吸取溶解液至培养皿中,顺时针摇匀


5. 在显微镜下观察细胞状态并记录
6. 放入二氧化碳细胞培养箱中培养,18h 后更换完全培养基

一、收到冻存细胞怎么处理
1. 收到冻存细胞后,请打开包装箱

2. 检查箱内干冰是否充足,冻存管是否融化

3. 若已经融化,请拍照留存,并于 24h 内联系客服

4. 若无异常,请及时将冻存管置于超低温冰箱内保存

5. 若长时间不使用,必须在超低温冰箱内过夜后转移至液氮中保存

二、冻存细胞复苏

1. 100mm 培养皿做好标记

2. 加入预热好的 12ml 完全培养基


3. 将冻存管放入 37℃ 水浴锅中,轻轻摇晃冻存管,待细胞悬液完全溶解后,转移至安全柜中操作

4. 用无菌吸管吸取溶解液至培养皿中,顺时针摇匀

5. 在显微镜下观察细胞状态并记录

6. 放入二氧化碳细胞培养箱中培养,18h 后更换完全培养基






